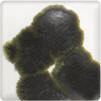
Pewter Crystals

Clearance
Pewter Crystals
These resemble small, dry coloured rocks that can be mixed with either clear glaze, glaze, or underglaze. The crystals will melt and flow during firing to achieve a wide variet of colour combinations and results.
MPN SPCR100
Brand:
Spectrum Glazes
Category:
Spectrum Glazes
Guaranteed
safe
checkout





These resemble small, dry coloured rocks that can be mixed with either clear glaze, glaze, or underglaze. The crystals will melt and flow during firing to achieve a wide variet of colour combinations and results.
MPN SPCR100

To install this Web App in your iPhone/iPad press
![]() and then Add to Home Screen.
and then Add to Home Screen.